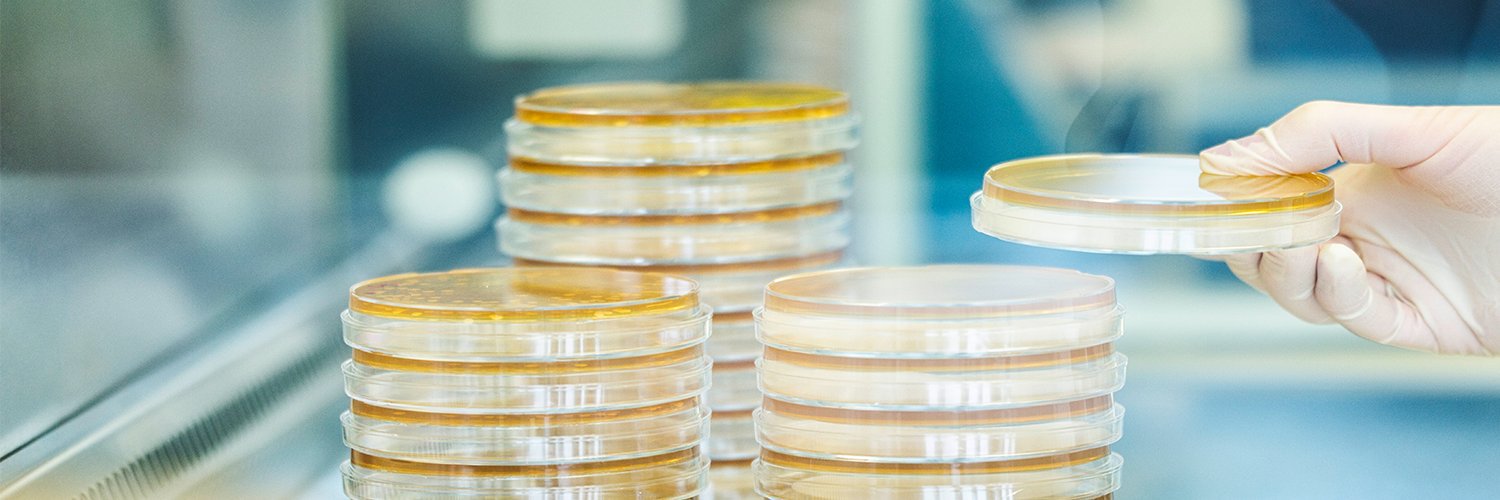
InfectControl banner

InfectControl
229 posts

@InfectControlDE
Gemeinsam stark gegen Infektionen | Wissenschaft, Wirtschaft, Gesellschaft Forschung zu Prävention, Diagnose, Therapie - One Health (gefördert vom @BMBF_Bund)



















Unsere neue #Antibiotika-Podcast-Folge zur infektiösen #Endokardidis mit @hagel_stefan ist raus. #IDtwitter #MedEd #FOAM Wie immer auf allen gängigen Plattformen! podcasts.apple.com/de/podcast/inf…




Das #Patientenzimmer der Zukunft wurde heute in #Braunschweig eröffnet! Hier forschen #TUBraunschweig, Fraunhofer IST und Städtisches #Klinikum Braunschweig gemeinsam in einem begehbaren Modell eines Zweibettzimmers, um künftig Infektionen zu verhindern. 👉lnk.tu-bs.de/GdHSTi






If there is one branch of science that has managed to infiltrate our everyday lives in the last two years, it is undoubtedly #InfectionResearch! 🦠 🧑🔬 We are therefore particularly pleased to be supported by the research network @InfectControlDE. 🤝 📸#LeonieLindl